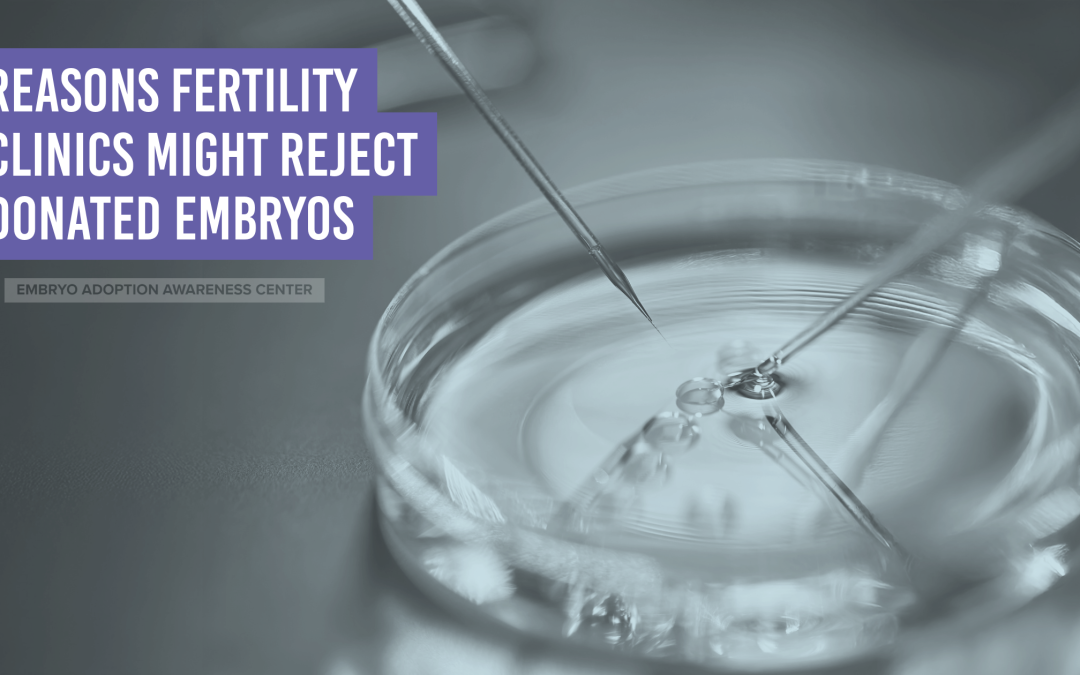

Embryo adoption and donation can be a wonderful option for individuals and couples hoping to build their families. However, not all donated embryos are accepted by fertility clinics for use by adoptive families. There are several medical, legal, and ethical reasons why a clinic may determine that an embryo is not suitable for transfer.
Here are some key reasons why a fertility clinic might reject donated embryos for a patient:
1. Embryo Quality and Viability
One of the primary reasons a clinic may reject donated embryos is poor quality. If the embryos were not graded highly at the time of freezing or have shown deterioration over time, they may be viewed by clinics as having a lower chance of implantation and a higher risk of miscarriage. Even though healthy babies have been born from embryos of all grades, clinics strive to provide their patients with embryos that they perceive have the best chance of resulting in a successful pregnancy.
2. Genetic and Medical Concerns
Fertility clinics will often recommend their patients to be genetically screened to minimize the risk of passing on genetic disorders. If the embryos come from an embryo donor with a known hereditary condition or lack a thorough medical history, the clinic may decline them. Additionally, if preimplantation genetic testing (PGT) reveals chromosomal abnormalities, the clinic may decide against embryo transfer.
3. Inadequate Screening of the Embryo Donors
For embryo adoption to proceed, the original embryo donors must meet specific standards set by the Food & Drug Administration. If the embryo donors were not adequately screened at the time of embryo creation or their medical history is incomplete, the clinic may reject the embryos to ensure the safety of the intended parents and potential child.
4. Legal Restrictions
Embryo adoption and donation is subject to various legal and ethical guidelines that vary by state within the U.S. If the necessary legal agreements between the donors and recipients are not properly completed, or if there are concerns about consent, the clinic may be unable to proceed with the adoption.
5. Embryo Storage and Thawing Issues
The method of embryo freezing (cryopreservation) can impact whether an embryo remains viable after thawing. If the embryos were frozen using outdated techniques or stored under suboptimal conditions, they may not survive the thawing process, leading the clinic to reject them in advance.
6. Clinic Policies and Accreditation Standards
Every fertility clinic has its own policies regarding embryo adoption and donation. Some clinics only accept embryos created at their facility’s lab, while others adhere to accreditation standards that require donated embryos to meet specific criteria. If the donated embryos do not align with the clinic’s policies, they may not be accepted.
7. Compatibility with the Patient
Certain medical factors of the adoptive mother, such as uterine abnormalities or immune system disorders, may influence a clinic’s decision. In some cases, the clinic may advise against using certain embryos based on the recipient’s reproductive health.
While embryo adoption provides a unique and meaningful path to parenthood for many families, fertility clinics must carefully evaluate each donated embryo to maximize success rates and protect the health of both the adoptive family and the future child.
If a clinic rejects donated embryos, it does not necessarily mean there are no options available. Intended parents can explore alternative fertility clinics, additional screening processes, or other embryo adoption or donation programs to find a match that meets medical, ethical, and legal standards.
The Snowflakes program accepts all embryos and works with many clinics that are flexible in their requirements for the embryos they will accept into their facilities. Snowflakes staff also ensure that all legal and medical requirements have been met before matching embryos with adopters.
To learn more about embryo adoption and donation, visit EmbryoAdoption.org.

Recent Comments